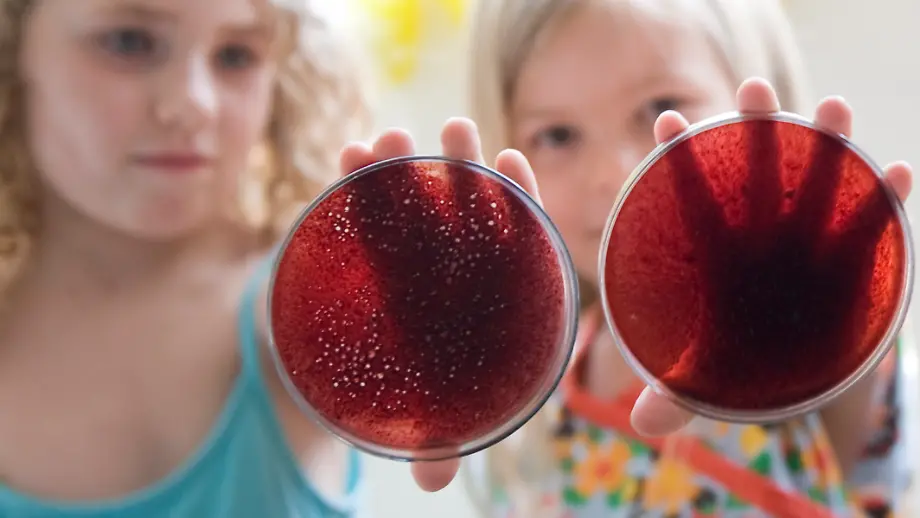
Video poster

Video
Rechtsanspruch ab 2013Kita-Plätze reichen noch lange nicht
30.05.2012, 16:47 UhrIn der Koalition ist der Streit um das von der CSU vorangebrachte Betreuungsgeld noch nicht beigelegt, da muss sich Bundesfamilienministerin Kristina Schröder auch noch um den Ausbau von Kita-Plätzen kümmern. Seit Jahren fehlen Angebote für Kinder, insbesondere für Kinder unter 3 Jahren. Nun hat das Kabinett ihr 10-Punkte-Programm gebilligt.
Topvideos